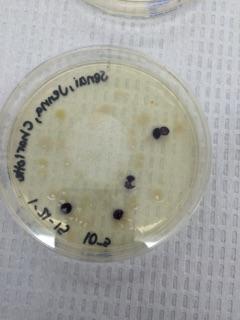
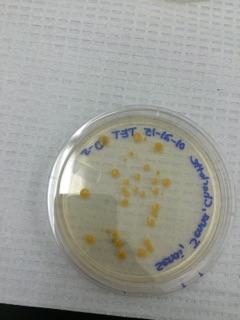

User:Charlotte Raley/Notebook/Biology 210 at AU
March 4th, 2015 -CR
Introduction:
Zebrafish are the perfect model organism for human experimentation. This species of fish very closely models human development and disease progression. Because the embryos are clear, it is easy to monitor development under a microscope. These fish are used very often in medical research and have been very useful in infectious disease studies (“Why Zebrafish?”, 2015). This lab covers our methods and observations of the effect of an alcohol living environment on Zebrafish development. They are extremely sensitive to their surroundings and are perfect for observing stages of development (“Embryogenesis”, 2015). In humans, if a fetus is exposed to alcohol while in the womb, there is a good chance that the child will be born with birth defects or some kind of serious mental or physical condition. Many of these children are born with Fetal Alcohol Sydrome (FAS). Often, the baby will die even before being born. FAS can cause a variety of problems depending on the person. Babies born with birth defects will have life-long problems that aren’t typically noticeable immediately right after birth. Some will have actual physical defects and some will have brain damage. These would include a lower than average IQ, delays in development, and social/behavioral problems, such as ADHD (Attention deficit-hyperactivity disorder). ADHD is common in children who also suffer from FAS (“Can Alcohol Affect a Baby During Pregnancy?”, 2014). ADHD causes children to have difficulties paying attention and staying on task. We assume that alcohol will have similar effects on a hatching Zebrafish egg. We hypothesized that if we used diluted alcohol (1.5%) in place of the controlled living environment (water), then Zebrafish behavior would be impacted. We predicted that the Zebrafish in the test group would have some noticeable physical and mental defects compared to those in the control group.
Materials/Methods:
Two groups of 20 Zebrafish embryos were put into two separate petri dishes. One was filled with 20mL of Deerpark water and the other was filled with 20mL of diluted alcohol. On the fifth day, 10mL of water were removed and 25mL of fresh water was put in. The same was done with alcohol for the experimental group. On day 5, one Zebrafish from the control group was put into paraformaldehyde and one Zebrafish from the experimental group was put into the chemical for observation at a later date. On day 7, 5mL of water were removed and 5mL of water were put in its place. Once again, the same was repeated with alcohol for the experimental group. At the rest of the intervals, 5mL of solution were taken out of both petri dishes and 10mL were put back into each one. The fish were observed, given food (one small drop of paramecium each observation day after one week),and moldy egg cases/dead bodies were removed as necessary. Final observations were made 14 days after the experiment was started.
Results:
We found that being exposed to an alcohol environment has a detrimental effect on Zebrafish. The majority of the fish in the experimental group died and they were definitely both physically and mentally effected.
Table 1: The color of the fish in the control turned green, while the fish exposed to alcohol only turned clear and white. Table 2: The control group fish moved fast, but in a linear direction, while the fish exposed to alcohol moved quick and spastically. Table 3: The control group fish grew larger in length than the experimental group which only grew to about 1/3 the size. Table 4: The heart rate of the control group stayed normal throughout the entire experiment, while the experimental group's started and stayed at a lower rate.
Table 5: The eye size of the control group was larger than those of the experimental group. Table 6: The Zebrafish in the experimental group had much faster eye movements than those in the control. Table 7: The yolk sac took the experimental group much longer to disappear than the control. Table 8: The experimental group never developed any mouth definition, while the control group had one at the end of two weeks.
Table 9: Swim bladder on alcohol exposed fish is much smaller and developed later than those in the control group. Table 10: Pectoral fin never developed in experimental group. Table 11: Throughout the experiment, only 5 of the control group fish died, while the majority of the experimental group did.
Conclusion:
Alcohol absolutely has an effect on the development of Zebrafish. The Zebrafish in the experimental group were hyperactive and swam much faster and seemed more jittery than the control group. The alcohol seems to have a similar effect on Zebrafish as it does on human embryos.
References:
"Can Alcohol Affect a Baby during Pregnancy?" Parenting and Child Health. Government of South Australia, 28 Aug. 2014. Web. 03 Mar. 2015. “Embryogenesis Experiment with Zebrafish Larvae” General Biology II. Meg Bentley, Kathryn Walters-Conte, Nancy K. Zeller. Print. 2015. Why Zebrafish? (2015, January 1). Retrieved March 3, 2015.
February 25th, 2015 -CR
Species: Pseudomonas sp.
Forward Sequence
NNNNNNNNNNNNNNNCNANNNATGCAGTCGAGCGGATGACGGGAGCTTGCTNTCNNGATTCAGCGGCGGACGGGTGAGTA ATGCCTAGGAATCTGCCTGGTAGTGGGGGACAACGTCTCGAAAGGGACGCTAATACCGCATACGTCCTACGGGAGAAAGC AGGGGACCTTCGGGCCTTGCGCTATCAGATGAGCCTAGGTCGGATTAGCTAGTTGGTGAGGTAATGGCTCACCAAGGCGA CGATCCGTAACTGGTCTGAGAGGATGATCAGTCACACTGGAACTGAGACACGGTCCAGACTCCTACGGGAGGCAGCAGTG GGGAATATTGGACAATGGGCGAAAGCCTGATCCAGCCATGCCGCGTGTGTGAAGAAGGTCTTCGGATTGTAAAGCACTTT AAGTTGGGAGGAAGGGCATTAACCTAATACGTTAGTGTTTTGACGTTACCGACAGAATAAGCNCCGGCTAACTCTGTGCC AGCAGCCGCGGTAATACAGAGGGTGCAAGCGTTAATCNNAATTACTGGGCGTAAANCGCNCGTNNNTGGTTTGGGGNAGT TCCATATGAAAGCCCCTCGGTCTACCCNGGGGGGGGGCGGT
Reverse Sequence
NNNNNNNNNNNNNGNNNNACCGTCCCCCCGNNNGNNAGACTAGCTACTTCTGGNNNNCCCACTCCCATGGTGTGNCGGGC GGTGTGTACAAGGCCCGGGAACGTATTCACCGCGACATTCTGATTCGCGATTACTAGCGATTCCGACTTCACGCAGTCGA GTTGCAGACTGCGATCCGGACTACGATCGGTTTTGTGGGATTAGCTCCACCTCGCGGCTTGGCAACCCTCTGTACCGACC ATTGTAGCACGTGTGTAGCCCAGGCCGTAAGGGCCATGATGACTTGACGTCATCCCCACCTTCCTCCGGTTTGTCACCGG CAGTCTCCTTAGAGTGCCCACCATTACGTGCTGGTAACTAAGGACAAGGGTTGCGCTCGTTACGGGACTTAACCCAACAT CTCACGACACGAGCTGACGACAGCCATGCAGCACCTGTCTCAATGTTCCCGAAGGCACCCATCCATCTCTGGAAAGTTCA TTGGATGTCAAGGCCTGGTAAGGTTCTTCGCGTTGCTTCGAATTAAACCACATGCTCCACCGCTTGTGCGGGCCCCCGTC AATTCATTTGAGTTTTAACCTTGCGGCCGTACTCCCCAGGCGGTCAACTTAATGCGTTAGCTGCGCCACTAAGAGCTCAA GGCTCCCAACGGCTAGTTGACATCGTTTACGGCGTGGACTACCANGGTATCTAATCCTGTTTGCTCCCCACGCTTTCGCA CCTCAGTGTCAGTATCAGTCCAGGTGGTCGCCTTCGCCACTGGTGTTCCTTCCTATATCTACGCATTTCACCGCTACACA GGAAATTCCACCACCCTCTACCATACTCTANCTTGTCAGTTTTGAATGCAGTTCCCANGTTGAGCCCGGNGCTTTCACAT CCAACTTAACAAACCACCTACGCGCGCTTTACGCCCAGTAATTTCCNANTAACGCTTGCACCCTCTGTATTACCNTCGNC TGCTGGCACANNNNTANNNGGTGCTTANTTCTGNCNGTNACGTCAAAACACTAANGTANTNNNNNATGCNCTTCCTCCCN NCTTNAANNTGCTTTNNNNTNNNNANNACCNTCNTCACNCNNCNGCATNNNGGATCAGGNTNTTNNNNNNTNGNNCAANA TTGCNNNANNNCTNCNNNCNGNANGNNN
We found that our species of bacteria was gram-negative pseudomonas sp. Pseudomonas tend to live in moist environments (our transect was marsh), so it makes sense that we would find it living in our area. Gram negative bacteria are known for causing infections in humans. Many bacteria in the Pseudomonas family are found in hospitals and many patients catch nosocomial infections from them ("Pseudomonas and Related Infections", 2015).
References:
Bush, Larry M., MD, and Maria T. Perez, MD. "Pseudomonas and Related Infections." Merck Manuals. Merck Sharp & Dohme Corp., Mar. 2014. Web. 4 Mar. 2015.
February 18th, 2015 -CR
Invertebrates from the Marsh at AU
Purpose/Introduction: In this week's lab, we observed and identified the invertebrates that were collected from our Burlese funnel that was set up last week.
Materials/Methods: We broke down the funnel and poured the top 15mLs of liquid and organisms into a petri dish. About 15mLs of the remaining liquid was poured into a second petri dish and labeled. The rest of the remaining liquid was kept on the side just in case we needed more observations later in the lab. We then looked at both petri dishes under dissecting microscopes to identify organisms from our transect. We also observed a cross section of Planaria yolk that were recently fed to see the digestive tract. We used an online key to determine what the organisms were: http://www.hope.edu/academic/biology/leaflitterarthropods/
Results: We were unable to observe movement in the cross sections because they were prepared slides and obviously dead. However, we did see what it looks like as it goes through the digestive tract by looking at the different slides, it just was not in real time. The five invertebrates that we observed were Homoptera hopper, Collembola striped springtail, anthropoda insecta, nematoma, and isopoda. The size ranges were all very similar ranging from 3 to 9mm, with one being quite a bit larger at 60 mm. The Isopoda was the largest organism measured from our transect. The Collembola striped springtail was the smallest organism measured from our transect. The most common organism found in our leaf litter was anthropoda insecta, which makes sense because they are termites.
 Figure 2 *Collembola striped springtail*
Figure 2 *Collembola striped springtail*
 Figure 3 *Anthropoda insect (termite)*
Figure 3 *Anthropoda insect (termite)*
Conclusion:
A common vertebrate that could be found in our transect is the killdeer species of bird (Charadrius vociferus). Another bird species could be the Eastern Whip-poor-will (Caprimulgus vociferus). Killdeer eat invertebrates and Eastern Whip-poor-will like low branches and nesting on the ground, which fits in our transect. Both species would benefit from both the abiotic factors (leaves, branches, etc.) and the biotic factors (invertebrates and small animals that most likely run through the transect every once in a while). The Eastern gray squirrel (Sciurus Carolinensis), Brown rat (rattus norvegicus), and Opossum (didelphimorphia) are all possible species that could cross through the transect. Each of these 5 species will have a carrying capacity in the niche which is the maximum number of each species that can sustainably live there and survive. These are all a community because they live in the same area and all interact with each other. Some of these species are higher up in the food chain (trophic levels) than others, as shown in figure 6.
February 11th, 2015 -CR
Characterizing Plants from the Marsh at AU
Purpose/Introduction: In this week's lab, we observed samples from our marsh transect, set up a Burlese funnel for next week's lab, and observed the cell structures of several different fungi.
Materials/Methods: We first went back to our transect and collected 5 samples of plants growing there in a plastic bag. We brought out another plastic bag to collect a sample area of ground cover to set up the Berlese funnel experiment for next week. 500 grams of leaf matter was put at the top of the funnel. At the bottom of the funnel there was a piece of screening material taped to the sides. The funnel led to a tube containing a preservative to collect invertebrates that might fall from the leaf matter. The funnel was then placed on a ring stand with a light source over top and was then left sitting for a week. We also observed several types of fungi under a microscope to observe the structures. We then observed some fungi samples in lab and identified their major groups.
Results: Plant #1 was found on the north side of the transect, slightly up the hill. I would guess that this plant is Feather Reed Grass or something very similar to it based on an article from GardenGuides.com (Earle,2010). It is a seedless plant about 3 feet tall. It is long and thin with fern-like projections. Plant #2 was found towards the north side of the transect as well. It is an angiosperm that is about 1.5 feet tall with scattered flowers around the stem. Plant #3 was found towards the east side of the transect, near the sidewalk. It is an angiosperm that is about 4 feet tall. It has a brown stem and is actually a Typha ("Native Freshwater Plants, 2015). Plant #4 was found in the middle/west side of the transect. It is an angiosperm that is also about 4 feet tall and has thick stems. Plant #5 was found on the west side of the transect near the grass. It is an angiosperm with short, red stems resembling shrubbery. All were vascular plants.
File:Transect Sample Plants.pdf Table 1
 Figure 1 *The 5 samples from our transect (cross sections)*
Figure 1 *The 5 samples from our transect (cross sections)*
 Figure 2 *Rhizopus Nigerians fungus* Zygomycota group
Figure 2 *Rhizopus Nigerians fungus* Zygomycota group
 Figure 3 *Mushroom we observed under a microscope (fungus)* We know this is a fungus because it has specialized branches on the underside of the mushroom cap. Basidiomycota group.
Figure 3 *Mushroom we observed under a microscope (fungus)* We know this is a fungus because it has specialized branches on the underside of the mushroom cap. Basidiomycota group.
 Figure 4 *Rhizopus stolonifer zygospore* Ascomycota group
Figure 4 *Rhizopus stolonifer zygospore* Ascomycota group
Conclusion: Plant #1 had no leaves, just tiny branches jutting out on the sides, like spores. Plant#2 had very small leaves that were in little clusters along the sides of the twig. They were light brown and in the shape of a "V". Plant #3 did not have leaves, just the white, airy seeds. Plant #4 did not have leaves, but did have flowers that were light yellow and very small, sort of in the shape of a dandelion. Plant #5 had very small leaves that were in little clusters at the very end of the twig. They were in the typical flower shape. Of our samples with seeds, I think that all were monocots because the flowers/leaves were always in multiples of three. The fungal sporangia are just the cells on a fungus that contain the spores. This is how the fungus asexually reproduces and this is the location of the mitosis/Meiosis process ("Asexual Sporangia, n.d.").
References:
"Asexual Sporangia." Asexual Sporangia. New Brunswick Museum, n.d. Web. 11 Feb. 2015.
Earle, Christopher. "Wheat Like Ornamental Grasses." GardenGuides. DemandMedia, 2010. Web. 11 Feb. 2015.
"Native Freshwater Plants." Cattail. State of Washington Department of Ecology, n.d. Web. 09 Feb. 2015.
February 4th, 2015 -CR
Observing Antibacterial Resistance
Purpose/Introduction: The purpose of the lab this week was to observe the growth of bacteria when put in the presence of an antibiotic and when put in a nutrient-rich environment. Last week we set up eight plates of samples from our Hay Infusion Culture. Four contained an antibiotic and four were just contained nutrient agar. We hypothesized that little to no bacteria would grow in the plates containing Tetracycline. If the hypothesis is correct, we will not be able to identify any organisms on those four plates under the microscope. I don't think that any Archaea will have grown on the agar plates because they grow in extreme environments. I don't think that the marsh area is considered an extreme environment.
Materials/Methods: We first retrieved our eight plates and counted the number of bacteria colonies growing on the plates. We chose 3 plates that contained the nutrient agar and 1 plate that contained the tetracycline to observe. We then made wet mounts and gram stains of the four samples. To make a gram stain, we sterilized a loop over a flame and scraped up some growth from the agar. We then added a drop of water to the slide. We then heat fixed the slide by passing it over a flame a few times. Then we followed the directions on the gram stain instruction paper covering the slides with Gram's iodine, crystal violet, alcohol, and safranin. We then looked at them under a microscope. Then, we set up the PCR procedure for next week's lab. We transferred a single colony of the bacteria of from the nutrient agar plate and one colony from the Tetracycline plate. We put them each in their own tube with 100μL of water. Then we incubated them at 100°C for 10 minutes in a heat block making sure the tubes were floating. Then we centrifuged the samples for 5 minutes at 13,400 rpm. During this time, we added 20μL of a primer/water mixture to a labeled PCR tube. Then mixed to dissolve the PCR bead. Then we transferred 5μL of supernatant from the centrifuges samples to the PCR reaction and placed the tube in the PCR machine.
Results: We took one last look at the Hay Infusion Culture and noticed that it had changed in appearance and smell. It is now odorless and clear colored on top. The debris in the jar completely settled on the bottom. We hypothesized that the appearance and odor may have changed due simply to time or because of microorganisms feeding on the remaining plant life and then dying. There were bacteria in all four nutrient agar plates. Although there was much less, we still found bacteria in two of the Tetracycline plates as well. We did not see any fungi in any of the eight plates. We didn't really notice a difference in the colony types in the different plate types.
 Figure 1 *Our 10^-3 Nutrient Agar Plate*
Figure 1 *Our 10^-3 Nutrient Agar Plate*
Figure 2 *Our 10^-5 Nutrient Agar Plate*
Figure 2 *Our 10^-5 Nutrient Agar Plate*
 Figure 3 *Our 10^-7 Nutrient Agar Plate*
Figure 3 *Our 10^-7 Nutrient Agar Plate*
Figure 4 *Our 10^-5 Tetracycline Plate*
Figure 4 *Our 10^-5 Tetracycline Plate*
 Figure 5 *Our marsh sample after sitting for one week*
Figure 5 *Our marsh sample after sitting for one week*
 Figure 6 *40x of 10^-5 nutrient sample*
Figure 6 *40x of 10^-5 nutrient sample*
 Figure 7 *40x of 10^-3 nutrient sample*
Figure 7 *40x of 10^-3 nutrient sample*
 Figure 8 *40x of 10^-7 nutrient sample*
Figure 8 *40x of 10^-7 nutrient sample*
 Figure 9 *40x of 10^-5 tetracycline sample*
Figure 9 *40x of 10^-5 tetracycline sample*
Data Tables:
Conclusion/Discussion: We definitely had data that was a little off and not completely consistent with our hypothesis. The fact that we did not see a difference in the colony types between the two plates could indicate that something was done incorrectly when making the plates last week. Overall, Tetracycline did have an effect on the bacterial growth. Much less bacteria was able to grow in the antibiotic plates. I would guess from our data that there aren't any bacteria that are unaffected by Tetracycline. Fungi may not be affected by it, but we didn't have any in our marsh sample, so that isn't conclusive data. Tetracyclines don't simply kill bacteria, they inhibit them by stopping the steps of protein synthesis and causing the cytoplasmic membrane to disintegrate. They are used against a variety of bacteria including richettsia and spirochetes ("Tetracycline - Antimicrobial Properties").
References: "Tetracycline - Antimicrobial Properties." Tetracycline - Antimicrobial Properties. N.p., n.d. Web. 04 Feb. 2015.
January 28, 2015 -CR
Identifying Protists From the Marsh at AU Purpose: The purpose of this lab was to identify what organisms were living in the sample that we took last week from the marsh area at AU.
Procedure/Materials:
First, we brought the jar back to our table without disrupting the solution. We then took a sample form the top of the solution and made a wet mount. Then we took a sample from the bottom of the solution and made a wet mount. We used the dichotomous key to determine what organisms (protists and algae) were living in our solution.
Data:
Species Size Color Movement Chilomonas sp. 31 micrometers Green Rotating fast in a circle Chlamydomonas 8 micrometers Green Fast Pelomyxa sp. 5 micrometers Green Very slow
Species Size Color Movement Colpidium sp. 50 micrometers Clear/gray Not moving Peranema sp. 2.5 micrometers Clear/gray Slow Chlamydomonas 6.25 micrometers Green Fast
C:\Users\Charlotte\AppData\Local\Packages\microsoft.windowscommunicationsapps_8wekyb3d8bbwe\LocalState\LiveComm\05c41f87a1ddfdde\120712-0049\Att\20003c14\20150128_162521.jpg
C:\Users\Charlotte\AppData\Local\Packages\microsoft.windowscommunicationsapps_8wekyb3d8bbwe\LocalState\LiveComm\05c41f87a1ddfdde\120712-0049\Att\20003c15\20150128_162907.jpg
Short Write Up:
When we opened our sample, we noticed a bad smell coming from the jar. There was not any visible life on the top of the liquid. It was a light green/brown color throughout with pieces of grass laying on the bottom of the jar. We saw little red dots on the top but were unsure if they were living or just part of the vegetation. From the top wet mount, we found Chilomonas sp., Chlamydomonas, and Pelomyxa. From the bottom wet mount we found Coldpidium sp., Chlamydomonas, and Paranema sp. All three organisms from the top sample are green and therefore, photosynthesizing.
Conclusion:
If the Hay Infusion was left to grow on its' own for another two months, I think we would find that only the creatures that could survive on their own would still be alive. The organisms that relied on plant life and sunlight/photosynthesis would die. According to natural selection, only the organisms that could survive long enough to reproduce would still be there. Organisms close to plant matter will feed on the plant matter to survive. The organisms that don't live near the plant matter are probably more likely to be self-sufficient. I think that the Paranema sp. probably meets all the needs for life living in the jar because it doesn't photosynthesize, so it seems to be able to survive on its' own. The other organisms that we saw are likely to die pretty soon because they won't have anything to feed on.
January 26, 2015 -CR
Marsh Life at AU
Purpose:
In this week's lab, we were put into groups and assigned a specific 20x20 ft transect around American University. Each group dug up a sample from their transect. We did a Hay infusion culture and using the sample, we observed the biotic and abiotic components. In later labs, we will use this sample to characterize the organisms found in these separate ecosystems around campus.
Procedure/Materials:
After being assigned to our transect (marsh area) we went outside and dug up a small amount of dirt/vegetation that was representative of the whole transect. The sample was placed into a 50 mL tube. We then weighed out 10-12 grams of the sample on a scale and placed it into a jar. Then, we measured out .1 gm of dried milk and 500 mLs of Deerpark bottled water and put it in the jar, then gently mixed the liquid for about 10 seconds. Then, we removed the lid of the jar, labelled the jar, and placed the container in a safe spot in the lab. The mixture will sit for a week.
Data:
[C:\Users\Charlotte\AppData\Local\Packages\microsoft.windowscommunicationsapps_8wekyb3d8bbwe\LocalState\LiveComm\05c41f87a1ddfdde\120712-0049\Att\20003be2\BIO EDITED20.jpg]
Short Write Up:
My group's marsh transect included a multitude of both biotic and abiotic factors. The biotic factors included grass, leaves, and bushes. The abiotic factors included a large rock, a lamp post, snow, dirt, dead vegetation, a sidewalk on the far west side, and a drain to the north. There were a lot more abiotic factors than biotic in our sample.
Conclusion:
The transect was on a slight hill. It was located on the hill across from Katzen Arts Center beside Kogod. We noticed that there was a lot of trash spread throughout as well. This and the drain could have affected the life in the transect. Most of the trash was towards the middle of the transect and towards the drain. We found that different characteristics in the environment affect what types of organisms live in that ecosystem.









